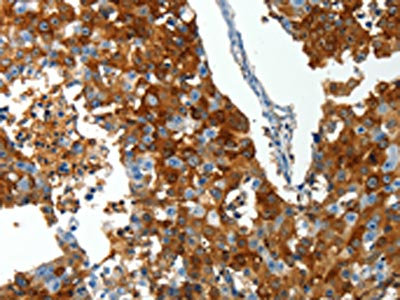

-
中文名稱:ABCG1兔多克隆抗體
-
貨號:CSB-PA139278
-
規格:¥1100
-
圖片:
-
The image on the left is immunohistochemistry of paraffin-embedded Human breast cancer tissue using CSB-PA139278(ABCG1 Antibody) at dilution 1/25, on the right is treated with synthetic peptide. (Original magnification: ×200)
-
The image on the left is immunohistochemistry of paraffin-embedded Human colon cancer tissue using CSB-PA139278(ABCG1 Antibody) at dilution 1/25, on the right is treated with synthetic peptide. (Original magnification: ×200)
-
Gel: 10%SDS-PAGE, Lysate: 40 μg, Lane: HT29 cells, Primary antibody: CSB-PA139278(ABCG1 Antibody) at dilution 1/300, Secondary antibody: Goat anti rabbit IgG at 1/8000 dilution, Exposure time: 40 seconds
-
-
其他:
產品詳情
-
Uniprot No.:
-
基因名:
-
別名:ABCG1; ABC8; WHT1; ATP-binding cassette sub-family G member 1; ATP-binding cassette transporter 8; White protein homolog
-
宿主:Rabbit
-
反應種屬:Human
-
免疫原:Synthetic peptide of Human ABCG1
-
免疫原種屬:Homo sapiens (Human)
-
標記方式:Non-conjugated
-
抗體亞型:IgG
-
純化方式:Antigen affinity purification
-
濃度:It differs from different batches. Please contact us to confirm it.
-
保存緩沖液:-20°C, pH7.4 PBS, 0.05% NaN3, 40% Glycerol
-
產品提供形式:Liquid
-
應用范圍:ELISA,WB,IHC
-
推薦稀釋比:
Application Recommended Dilution ELISA 1:2000-1:5000 WB 1:200-1:1000 IHC 1:25-1:100 -
Protocols:
-
儲存條件:Upon receipt, store at -20°C or -80°C. Avoid repeated freeze.
-
貨期:Basically, we can dispatch the products out in 1-3 working days after receiving your orders. Delivery time maybe differs from different purchasing way or location, please kindly consult your local distributors for specific delivery time.
-
用途:For Research Use Only. Not for use in diagnostic or therapeutic procedures.
相關產品
靶點詳情
-
功能:Catalyzes the efflux of phospholipids such as sphingomyelin, cholesterol and its oxygenated derivatives like 7beta-hydroxycholesterol and this transport is coupled to hydrolysis of ATP. The lipid efflux is ALB-dependent. Is an active component of the macrophage lipid export complex. Could also be involved in intracellular lipid transport processes. The role in cellular lipid homeostasis may not be limited to macrophages. Prevents cell death by transporting cytotoxic 7beta-hydroxycholesterol.
-
基因功能參考文獻:
- HSP70 suppresses the expression of ABCA1 and ABCG1 through preventing Elk-1 from binding to the promoter of ABCA1 and ABCG1 in human THP-1-derived macrophages. PMID: 29678642
- Downregulation of ABCG1 in macrophages promoted atherosclerotic lesions. PMID: 30393020
- High ABCG1 expression is associated with glioma. PMID: 26981778
- ABCG1 regulates pulmonary surfactant metabolism PMID: 28264879
- Hepatic free cholesterol content was significantly increased in NASH as compared to non-NASH subjects, while ABCA1 and ABCG1 protein levels significantly decreased with NASH and fibrosis progression. The relative expression of miR-33a and miR-144 correlated inversely with ABCA1 but not with ABCG1 protein levels. miR-33a/144 and their target gene ABCA1 may contribute to the pathogenesis of NASH in morbidly obese subjects. PMID: 26945479
- Understanding the relationship between cholesterol and inflammation in the lung, and the role that ABC transporters play in this may illuminate new pathways to target for the treatment of inflammatory lung diseases PMID: 28241820
- Findings suggest that the ABCG1-mediated efflux of cholesterol, but not of 7-ketocholesterol, shows specificity for structural domains of apoA-I bound to reconstituted HDL. Although the mid region alone of apoA-I associated to rHDL can promote ABCG1-mediated cholesterol efflux, deletion of carboxyl-terminal region 185-243 from full-length apoA-I diminishes ABCG1-mediated cholesterol efflux. PMID: 23826352
- ABCG1 regulates T cell differentiation into Tregs, highlighting a pathway by which cholesterol accumulation can influence T cell homeostasis in atherosclerosis PMID: 27482882
- ABCG1 and ABCG4 alter the distribution of gamma-secretase on the plasma membrane, leading to the decreased gamma-secretase activity and suppressed Abeta secretion PMID: 27196068
- Both the full-length and the short isoforms of ABCG1 can dimerize with ABCG4, whereas the ABCG2 multidrug transporter is unable to form a heterodimer with ABCG4. PMID: 27228027
- DNA methylation at the ABCG1 locus cg06500161 in blood DNA was associated with an increased risk for future type2 diabetes. PMID: 27148772
- we have newly identified a haplotype-tagging SNP, rs225396, in ABCG1 to be associated with PCV and nAMD in Chinese and Japanese cohorts. This provides new evidence to support ABCG1 as a susceptibility gene for PCV and nAMD. PMID: 27787563
- ABCG1 gene expression positively correlated with obesity indicators. PMID: 27420620
- Our results indicated that genetic variants of ABCG1 may be predictors of survival of nonsmall-cell lung cancer patients PMID: 26757251
- This review focuses on the role of ABC transporters A1 and G1 in the pathogenesis of atherosclerosis PMID: 27239842
- Leu at position 550/562 in mABCG1/hABCG1 is critical for their plasma membrane localization but not for ABCG1-mediated cholesterol efflux. PMID: 26695502
- ABCG1 polymorphisms are associated with reduced risk of developing ischemic stroke in hypertriglyceridemic population and atherothrombotic stroke in this cohort of Chinese Han population. PMID: 25890853
- Data suggest that ligand-induced activation of RAGE (advanced glycosylation end product-specific receptor) down-regulates ABCG1-mediated cholesterol efflux from macrophages leading to diabetic angiopathies and atherosclerotic plaques. PMID: 26253613
- Propofol up-regulates expression of ABCA1, ABCG1, and SR-B1 through the PPARgamma/LXRalpha pathway in THP-1 macrophage-derived foam cells. PMID: 25600616
- Expression analysis revealed an association between ABCG1 methylation and lipid levels that might be partly mediated by ABCG1 expression. PMID: 25583993
- HUWE1 and NEDD4-1 are two E3 ligases that are fundamental enzymes in the post-translational regulation of ABCG1 and ABCG4 protein levels and cellular cholesterol export activity PMID: 26296893
- These findings indicate that SNP rs1893590 of ABCG1 has a significant impact over HDL-C under asymptomatic clinical conditions in an age and BMI dependent way. PMID: 25398214
- ABCG1 promoter rs57137919G>A variant had an allele-specific effect on ABCG1 expression and was associated with an increased apoptosis in cholesterol-loaded macrophages. PMID: 24972087
- The present review summarizes the current knowledge and views on the regulatory role of CAV1 on the cholesterol homeostasis with emphasis on the association of CAV1 with ABCA1 and ABCG1. [review] PMID: 24801727
- Hyperalphalipoproteinemics present a decrease in hsa-miR-33a and higher mRNA expression of ABCA1 and ABCG1. PMID: 26051418
- ABCG1 can interact with cholesterol via a functional CRAC domain (cholesterol recognition/interaction amino acid consensus motifs). PMID: 25732853
- Ang-(1-7) upregulates ABCA1 and ABCG1 expression. PMID: 25225013
- These results suggest that ABCA1, ABCG1, and ABCG4 are localized to distinct membrane meso-domains and disturb the meso-domain structures by reorganizing lipids on the plasma membrane PMID: 25302608
- The role of cellular cholesterol transport proteins including adenosine triphosphate binding cassette transporter A1 (ABCA1), G1 (ABCG1) and scavenger receptor class B type I (SR-BI) in diabetic nephropathy, was determined. PMID: 25181357
- promoter DNA hypermethylation of the ABCG1 and GALNT2 genes, but not the HMGCR gene, is associated with an increased risk of CHD. PMID: 25084356
- The study identifies a major role of adipocyte ABCG1 in adiposity and fat mass growth and suggests that adipose ABCG1 might represent a potential therapeutic target in obesity. PMID: 25249572
- knock-outs display expansion of B-1 B cells, which secrete natural Abs that protect from atherosclerosis PMID: 25339664
- Decrease in the ABCG1 gene expression in macrophages is associated with atherosclerosis. PMID: 25509420
- I human macrophages, polyunsaturated fatty acids such as EPA have an effect on the cholesterol homeostasis in macrophages, and they can change the expression of ABCG1 gene. PMID: 24901717
- Generation of extracellular cholesterol microdomains is mediated by ABCG1. PMID: 24212237
- These findings indicate that CAV1 interacts with ABCG1 and regulates ABCG1-mediated cholesterol efflux. PMID: 24576892
- Data suggest that in placentas from women with pre-eclampsia, expression of ABCA1 (ABC transporter 1) is down-regulated in apical membrane of villous syncytiotrophoblast and in villous fetal endothelial cells; expression of ABCG1 is unchanged. PMID: 23880356
- results suggest that reduction of ABCG1 induces endothelial apoptosis, which seems associated with intracellular free cholesterol accumulation and subsequent ER stress PMID: 23897420
- Our results showed that CETP is a susceptibility gene for neovascular age-related macular degeneration and polypoidal choroidal vasculopathy (PCV) and that ABCG1 a putative gene for PCV. PMID: 24393350
- No significant associations were detected for the ABCB6 or ABCG1 gene PMID: 24192121
- ABCA1 and ABCG1 ubiquitination and degradation are regulated by cellular cholesterol PMID: 24500716
- MiR-128-2 inhibits the expression of ABCA1, ABCG1 and RXRalpha directly through a miR-128-2-binding site within their respective 3'untranslated regions. PMID: 23990020
- Two highly conserved residues, Asn and Phe, play an important role in ABCG1-dependent export of cellular cholesterol through the regulation of ABCG1 trafficking. PMID: 24320932
- LXRalpha plays a central role in neopterin-induced downregulation of ABCA1 and ABCG1 in THP-1 macrophage-derived foam cells. PMID: 23564066
- Our data suggest that MCP-1 impairs RCT activity in HepG2 cells by a PI3K/Akt-mediated posttranslational regulation of ABCA1, ABCG1, and SR-BI cell-surface expression. PMID: 23402987
- Evidence is presented for the first time suggesting that resveratrol is able to activate ABCG1 activity by an alternative mechanism that involves an indirect interaction PMID: 23770099
- Endothelial dysfunction induced by high glucose is associated with decreased ABCG1 expression. PMID: 22365996
- ABCG1 is an active lipid transporter and possesses different binding sites for cholesterol and sphingomyelin PMID: 23172659
- Genetic variations in ABCA1 and ABCG1 were not associated with increased risk of type 2 diabetes in the general population. PMID: 23139370
- These data indicate that ABCA1, ABCG1, and SR-BI are reduced in various populations under subclinically inflammatory conditions, which may potentially lead to impairing reverse cholesterol transport and developing atherosclerosis. PMID: 22614118
顯示更多
收起更多
-
亞細胞定位:Endoplasmic reticulum membrane; Multi-pass membrane protein. Golgi apparatus membrane; Multi-pass membrane protein. Cell membrane. Note=Predominantly localized in the intracellular compartments mainly associated with the endoplasmic reticulum (ER) and Golgi membranes.
-
蛋白家族:ABC transporter superfamily, ABCG family, Eye pigment precursor importer (TC 3.A.1.204) subfamily
-
組織特異性:Expressed in several tissues. Expressed in macrophages; expression is increased in macrophages from patients with Tangier disease.
-
數據庫鏈接:
Most popular with customers
-
-
YWHAB Recombinant Monoclonal Antibody
Applications: ELISA, WB, IHC, IF, FC
Species Reactivity: Human, Mouse, Rat
-
Phospho-YAP1 (S127) Recombinant Monoclonal Antibody
Applications: ELISA, WB, IHC
Species Reactivity: Human
-
-
-
-
-